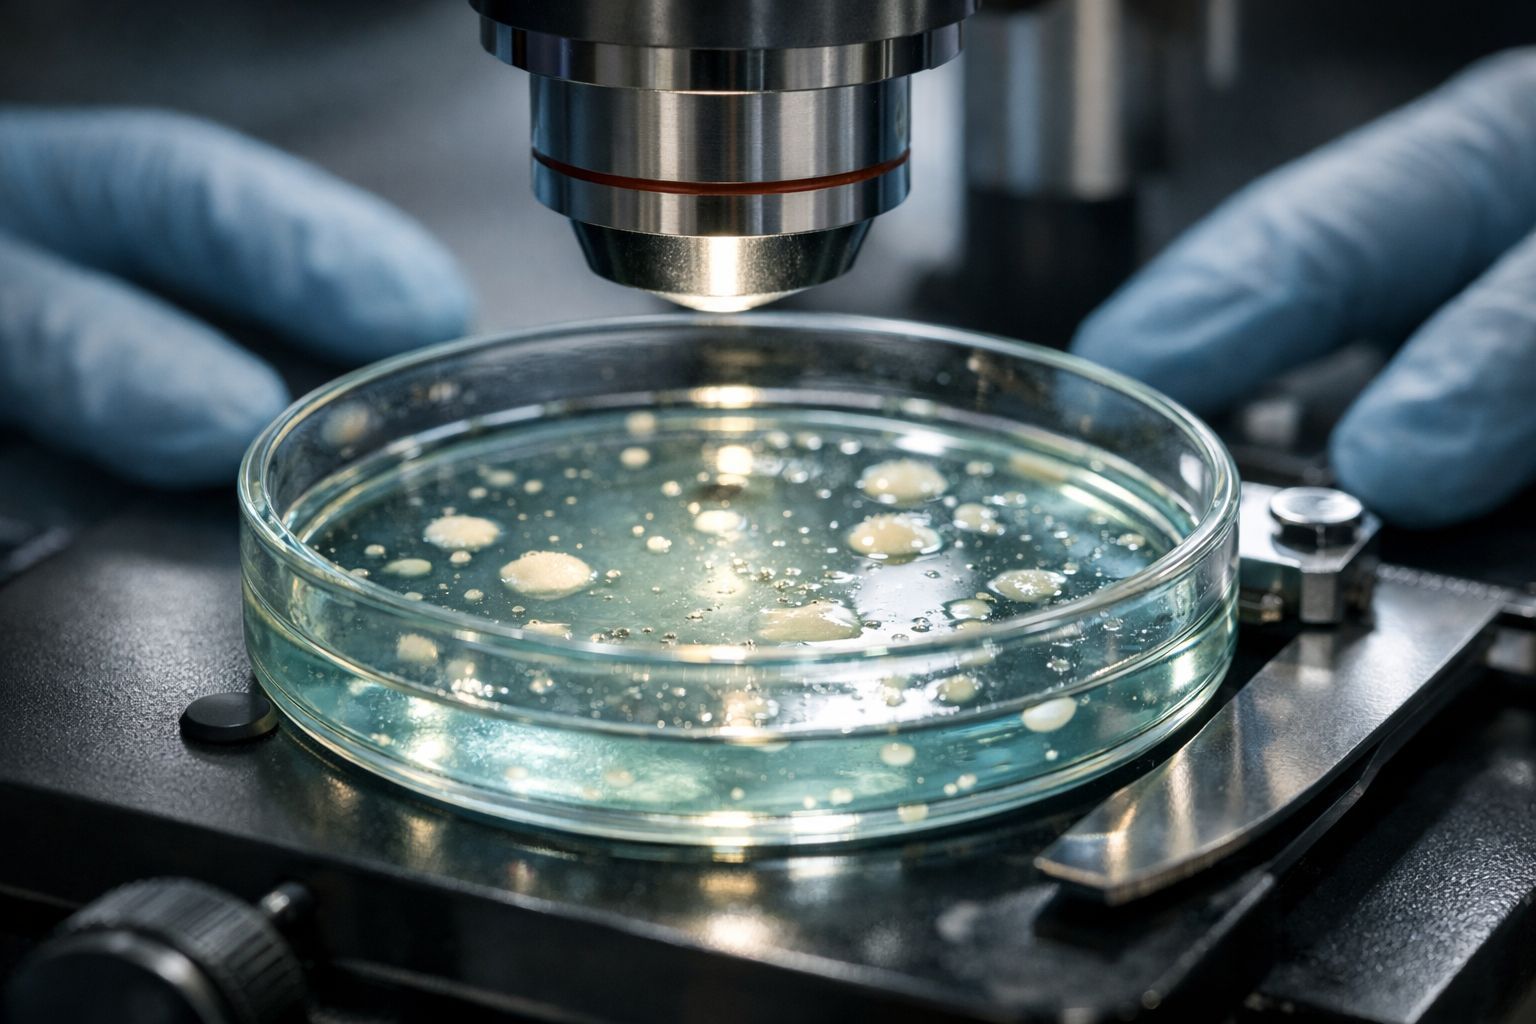

Alzheimer : un nouveau traitement pourrait-il enfin freiner la maladie ? Des résultats préliminaires qui redonnent espoir
Auteur: Adam David
Une lueur d’espoir venue d’Outre-Manche

C’est une réalité qui touche, de près ou de loin, presque chacun d’entre nous. En France, on estime qu’environ un million de personnes vivent aujourd’hui avec la maladie d’Alzheimer. Un chiffre vertigineux, n’est-ce pas ? Derrière cette statistique froide, il y a des familles bouleversées, des quotidiens chamboulés et une organisation des soins qui pèse lourdement sur notre société. On a souvent l’impression de piétiner face à ce fléau, d’attendre ce miracle médical qui tarde à venir.
Pourtant, il semblerait que les lignes bougent enfin. Récemment, une équipe de chercheurs britanniques a jeté un pavé dans la mare — ou plutôt, une bouée de sauvetage. Ces scientifiques anglais ont mis au point un médicament qui semble particulièrement prometteur. Leur découverte, qui a fait l’objet d’une publication scientifique toute récente, ne se contente pas de proposer un soulagement des symptômes ; elle laisse entrevoir la possibilité réelle de ralentir, voire de stopper net, la progression de la maladie. C’est audacieux, peut-être, mais les premiers signaux sont là.
Au cœur du cerveau : comprendre la stratégie du RI-AG03

Alors, comment ça marche concrètement ? Il faut se tourner vers l’université de Lancaster, au Royaume-Uni, pour comprendre cette potentielle révolution dans la prise en charge d’Alzheimer. Leurs équipes ont travaillé d’arrache-pied pour développer une nouvelle stratégie moléculaire. Ils ont fini par mettre au point un inhibiteur peptidique baptisé RI-AG03. Ce nom de code un peu barbare cache en réalité une mécanique de précision redoutable. L’action de ce composé vise des cibles très précises : des « points chauds » situés sur la protéine Tau. Vous en avez peut-être déjà entendu parler, car ces protéines sont des éléments majeurs dans le développement de ces enchevêtrements néfastes qui signent la maladie.
Pour faire simple — enfin, aussi simple que la neurologie le permet —, la protéine Tau joue un rôle central. En temps normal, elle est indispensable à la stabilité de nos neurones. Mais chez les malades d’Alzheimer, la machine s’enraye : ces protéines se déforment et s’agrègent, ce qui finit par perturber gravement la circulation des informations dans le cerveau. C’est cette terrible désorganisation qui, petit à petit, prive le cerveau de nutriments et coupe les communications neuronales, conduisant inexorablement à l’effacement des capacités cognitives. Les chercheurs ont réussi à identifier deux régions spécifiques de la protéine Tau responsables de ces amas toxiques. Le RI-AG03 a donc été conçu sur mesure pour se fixer sélectivement à ces zones, empêchant ainsi la formation des enchevêtrements dans les neurones touchés.
Des mouches aux cellules humaines : des preuves tangibles
On pourrait sourire en apprenant que les premiers bénéficiaires de cette avancée sont des insectes, et pourtant, les résultats sont là. Le traitement avec le RI-AG03 a été testé sur la mouche drosophile. Pourquoi la drosophile ? Parce qu’elle reste un modèle biologique de référence, aussi surprenant que cela puisse paraître. Et les signes d’efficacité sont, disons-le, assez bluffants. La dégénérescence neuronale chez ces insectes s’est trouvée stoppée. Mieux encore, leur longévité a augmenté de manière notoire. Ce n’est pas rien.
Les scientifiques ne se sont pas arrêtés à ces observations de surface. Des examens détaillés ont permis d’attester une nette réduction des fibres pathologiques dans le cerveau des sujets testés. Mais le plus encourageant, c’est probablement ce qui s’est passé lors des essais suivants. Les chercheurs sont passés à des modèles cellulaires humains. Le verdict ? Le traitement a montré une pénétration cellulaire effective et, surtout, une baisse très remarquée de l’agrégation de la protéine Tau. On a donc un médicament qui entre bien dans les cellules et qui fait le travail attendu. C’est une validation cruciale pour la suite.
Conclusion : Quelles sont les prochaines étapes ?
Bien sûr, il faut garder la tête froide. Nous ne sommes pas encore à la veille de trouver ce médicament en pharmacie, mais la route est tracée. Les prochaines expériences concerneront des rongeurs, une étape indispensable et préalable aux futures recherches sur l’être humain. C’est un processus long, rigoureux, mais nécessaire pour garantir la sécurité de tous.
Ce projet ambitieux, financé notamment par l’Alzheimer’s Society britannique, pose des bases particulièrement solides. Il ouvre la porte au développement de nouvelles thérapeutiques, non seulement face à Alzheimer, mais aussi potentiellement pour d’autres affections liées aux dysfonctionnements de la protéine Tau. L’espoir est permis, je crois.
Selon la source : passeportsante.net
Ce contenu a été créé avec l’aide de l’IA.